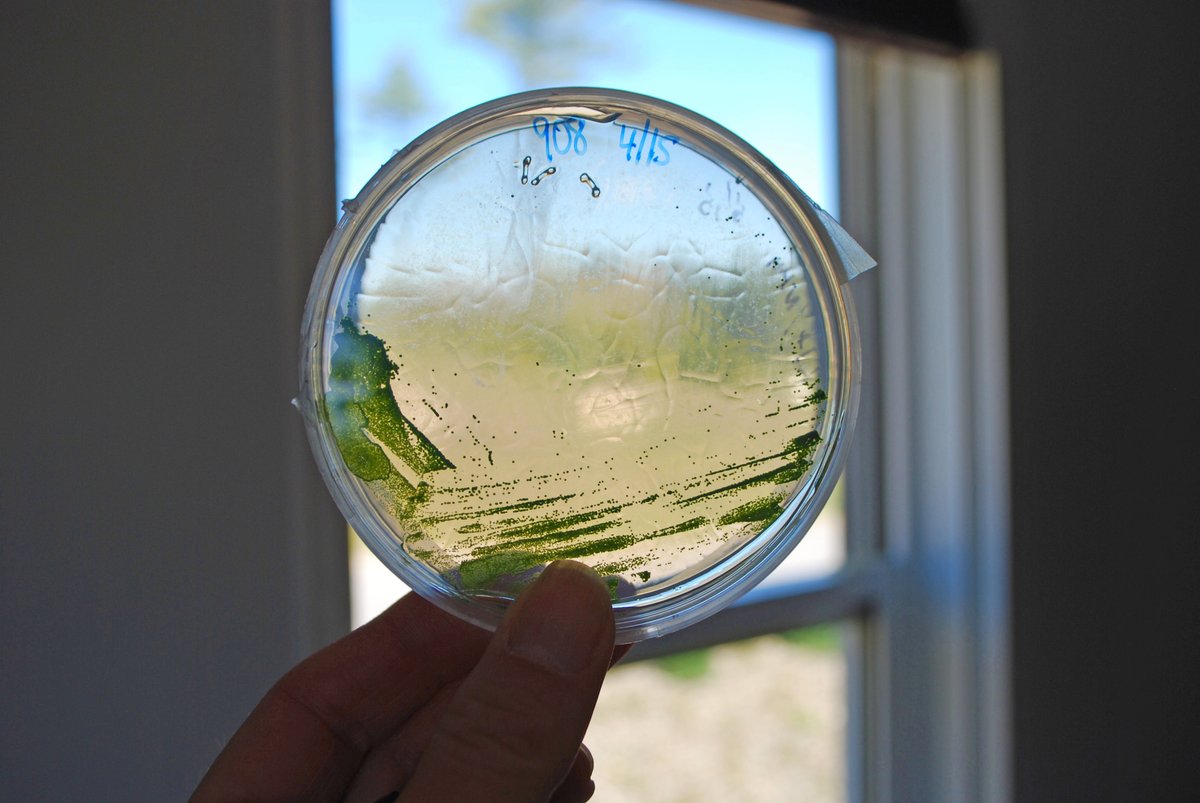
Bigelow Laboratory tweet media

Celebrating Partner-SHIP: A collaborative project featuring #BigelowLab SRS Nicole Poulton was awarded the 2024 Excellence in Partnering Award from the National Oceanographic Partnership Program. Learn more about the award-winning Bio-GO-SHIP project: bigelow.org/news/articles/…



English